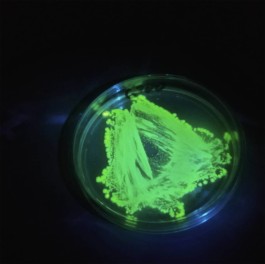
Justin Pape

Inoculum Ale Works
Design, Illustration
2016
Located in Florida, Inoculum is a sour beer brewery with a focus on strange and experimental mixtures. They have beer made with various fruits and spices, one with absinthe, one with green tea, one with cherry and iron that tastes like blood, and one using the bioluminescence of sea creatures that glows in the dark. With their labels, I wanted to create pieces of artwork that not only reflected what was in the can, but also had the elements of toungue and cheek that they put into their brewing process.

Drex the Lactosaurus Rex - An American style berliner weisss. A super sessional Berliner with meyer lemon notes and a mild fruit finish.

Mother Ursa - An American style old bruin. A large chocolate malt backbone with a very clean lactic acidity and a crisp, dry finish.

Dream Catcher - A absinthe sour farmhouse ale. Spicy aromatics, a mild earthiness, and a mild fruit finish



Spectrally Macabre - A rose brewed with watermelons, basil, Malden sea salt, and a special bitterness black malt.

Hāto Minka - A farmhouse ale blended with a beautiful Houjicha green tea.


Kuebiko - A sour ale with strawberries, lemons and limes. 100% of proceeds donated to help those involved with the Orlando Pulse shooting.

Blood Thirst - A special Berliner weirs brewed with black cherries and iron to satiate your occasional blood thirst.

Orange Blossom - A sour orange and honey beer in collaboration with Orange Blossom Brewering Co.

Parthenocarpic - A sour beer designed specifically to highlight local wild tangerines. Super clean lactic acidity with a heavy and intricate citrus kick.
